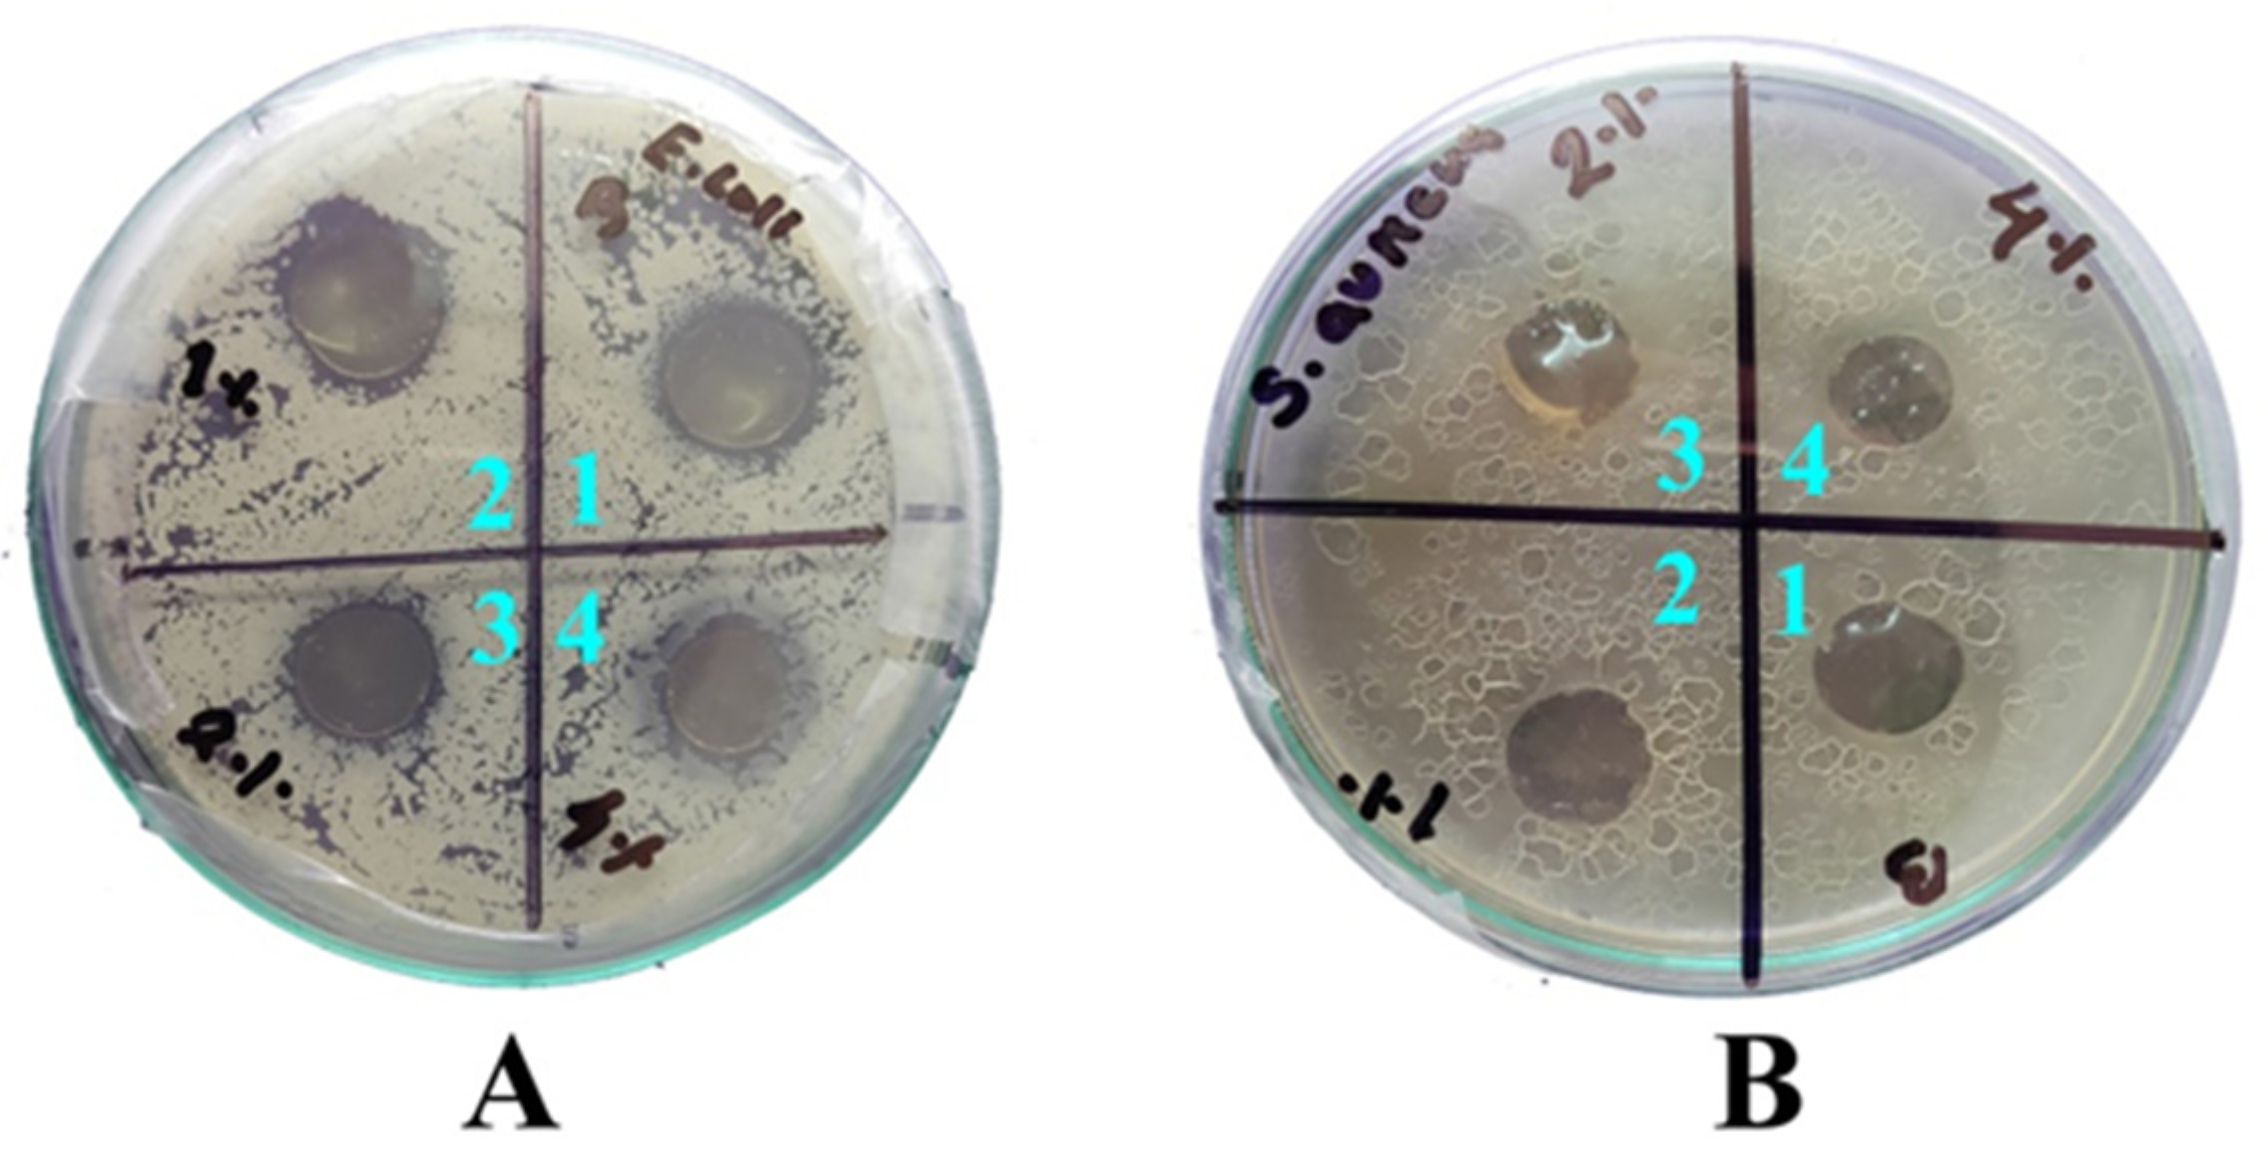
Foods 09 01143 g006

Biodegradable Hybrid Nanocomposite of Chitosan/Gelatin and Green Synthesized Zinc Oxide Nanoparticles for Food Packaging
Abstract
1. Introduction
2. Materials and Methods
2.1. Materials
2.2. Green Synthesis of ZnO Nanoparticles
2.3. Characterization of ZnO NPs
2.4. Fabrication of Hybrid Nanocomposite Film
2.5. Characterization of Nanocomposite Films
2.5.1. Thickness and Mechanical Properties
2.5.2. Microstructural Analysis
2.5.3. Infrared Spectroscopy
2.5.4. Thermogravimetric Analysis (TGA)
2.6. Antimicrobial Analysis
3. Results and Discussion
3.1. Characterization of ZnO Nanoparticles
3.2. Characterization of Hybrid Films
3.2.1. Textural Properties
3.2.2. Surface Morphology
3.2.3. FTIR Analysis
3.2.4. Thermal Stability
3.3. Antimicrobial Study
4. Conclusions
Author Contributions
Funding
Conflicts of Interest
References
- Negi, S.; Anand, N. Factors Leading to Losses and Wastage in the Supply Chain of Fruits and Vegetables Sector in India. In Energy Infrastructure and Transportation “Challenges and Way Forward”; Dhingra, T., Ed.; College of Management & Economics Studies, University of Petroleum & Energy Studies: Dehradun Uttarakhand, India, 2016; pp. I 89–I 105. [Google Scholar] [CrossRef]
- Kumar, S.; Mukherjee, A.; Dutta, J. Chitosan based nanocomposite films and coatings: Emerging antimicrobial food packaging alternatives. Trends Food Sci. Technol. 2020, 97, 196–209. [Google Scholar] [CrossRef]
- Kumar, S.; Ye, F.; Dobretsov, S.; Dutta, J. Chitosan Nanocomposite Coatings for Food, Paints, and Water Treatment Applications. Appl. Sci. 2019, 9, 2409. [Google Scholar] [CrossRef]
- Sharma, B.; Malik, P.; Jain, P. Biopolymer reinforced nanocomposites: A comprehensive review. Mater. Today Commun. 2018, 16, 353–363. [Google Scholar] [CrossRef]
- Kumar, S.; Mitra, A.; Halder, D. Centella asiatica leaf mediated synthesis of silver nanocolloid and its application as filler in gelatin based antimicrobial nanocomposite film. LWT 2017, 75, 293–300. [Google Scholar] [CrossRef]
- Moreno, M.A.; Orqueda, M.E.; Gómez-Mascaraque, L.G.; Isla, M.I.; López-Rubio, A. Crosslinked electrospun zein-based food packaging coatings containing bioactive chilto fruit extracts. Food Hydrocoll. 2019, 95, 496–505. [Google Scholar] [CrossRef]
- Duan, C.; Meng, X.; Meng, J.; Khan, M.I.H.; Dai, L.; Khan, A.; An, X.; Zhang, J.; Huq, T.; Ni, Y. Chitosan as A Preservative for Fruits and Vegetables: A Review on Chemistry and Antimicrobial Properties. J. Bioresour. Bioprod. 2019, 4, 11–21. [Google Scholar] [CrossRef]
- Priyadarshi, R.; Rhim, J.-W. Chitosan-based biodegradable functional films for food packaging applications. Innov. Food Sci. Emerg. Technol. 2020, 62, 102346. [Google Scholar] [CrossRef]
- Kumar, S.; Shukla, A.; Baul, P.P.; Mitra, A.; Halder, D. Biodegradable hybrid nanocomposites of chitosan/gelatin and silver nanoparticles for active food packaging applications. Food Packag. Shelf Life 2018, 16, 178–184. [Google Scholar] [CrossRef]
- Hanani, Z.A.N.; Roos, Y.H.; Kerry, J.P. Use and application of gelatin as potential biodegradable packaging materials for food products. Int. J. Biol. Macromol. 2014, 71, 94–102. [Google Scholar] [CrossRef]
- Garcia, C.V.; Shin, G.H.; Kim, J.T. Metal oxide-based nanocomposites in food packaging: Applications, migration, and regulations. Trends Food Sci. Technol. 2018, 82, 21–31. [Google Scholar] [CrossRef]
- Kumar, S.; Bhattacharya, W.; Singh, M.; Halder, D.; Mitra, A. Plant latex capped colloidal silver nanoparticles: A potent anti-biofilm and fungicidal formulation. J. Mol. Liq. 2017, 230, 705–713. [Google Scholar] [CrossRef]
- Kumari, R.; Brahma, G.; Rajak, S.; Singh, M.; Kumar, S. Antimicrobial activity of green silver nanoparticles produced using aqueous leaf extract of Hydrocotyle rotundifolia. Orient. Pharm. Exp. Med. 2016, 16, 195–201. [Google Scholar] [CrossRef]
- Kumar, S.; Boro, J.C.; Ray, D.; Mukherjee, A.; Dutta, J. Bionanocomposite films of agar incorporated with ZnO nanoparticles as an active packaging material for shelf life extension of green grape. Heliyon 2019, 5, e01867. [Google Scholar] [CrossRef]
- Al-Naamani, L.; Dobretsov, S.; Dutta, J. Chitosan-zinc oxide nanoparticle composite coating for active food packaging applications. Innov. Food Sci. Emerg. Technol. 2016, 38, 231–237. [Google Scholar] [CrossRef]
- Baruah, S.; Dutta, J. Hydrothermal growth of ZnO nanostructures. Sci. Technol. Adv. Mater. 2009, 10, 13001. [Google Scholar] [CrossRef] [PubMed]
- Król, A.; Pomastowski, P.; Rafińska, K.; Railean-Plugaru, V.; Buszewski, B. Zinc oxide nanoparticles: Synthesis, antiseptic activity and toxicity mechanism. Adv. Colloid Interface Sci. 2017, 249, 37–52. [Google Scholar] [CrossRef] [PubMed]
- Bandeira, M.; Giovanela, M.; Roesch-Ely, M.; Devine, D.M.; Crespo, J.S. Green synthesis of zinc oxide nanoparticles: A review of the synthesis methodology and mechanism of formation. Sustain. Chem. Pharm. 2020, 15, 100223. [Google Scholar] [CrossRef]
- Chakraborty, S.; Farida, J.J.; Simon, R.; Kasthuri, S.; Mary, N. Averrhoe carrambola fruit extract assisted green synthesis of zno nanoparticles for the photodegradation of congo red dye. Surfaces Interfaces 2020, 19. [Google Scholar] [CrossRef]
- Golmohammadi, M.; Honarmand, M.; Ghanbari, S. A green approach to synthesis of ZnO nanoparticles using jujube fruit extract and their application in photocatalytic degradation of organic dyes. Spectrochim. Acta Part A: Mol. Biomol. Spectrosc. 2020, 229, 117961. [Google Scholar] [CrossRef]
- Zikalala, N.; Matshetshe, K.; Parani, S.; Oluwafemi, O.S. Biosynthesis protocols for colloidal metal oxide nanoparticles. Nano-Structures Nano-Objects 2018, 16, 288–299. [Google Scholar] [CrossRef]
- Rahmani, A.H. Cassia fistulaLinn: Potential candidate in the health management. Pharmacogn. Res. 2015, 7, 217–224. [Google Scholar] [CrossRef] [PubMed]
- Sakulpanich, A.; Chewchinda, S.; Sithisarn, P.; Gritsanapan, W. Standardization and toxicity evaluation of Cassia fistula pod pulp extract for alternative source of herbal laxative drug. Pharmacogn. J. 2012, 4, 6–12. [Google Scholar] [CrossRef]
- Hafsa, J.; Smach, M.A.; Ben Khedher, M.R.; Charfeddine, B.; Limem, K.; Majdoub, H.; Rouatbi, S. Physical, antioxidant and antimicrobial properties of chitosan films containing Eucalyptus globulus essential oil. LWT 2016, 68, 356–364. [Google Scholar] [CrossRef]
- Ullah, R.; Dutta, J. Photocatalytic degradation of organic dyes with manganese-doped ZnO nanoparticles. J. Hazard. Mater. 2008, 156, 194–200. [Google Scholar] [CrossRef]
- Irshad; Mehdi, S.J.; Al-Fatlawi, A.A.; Yab, Z.; Ali, A.; Ahmad, I.; Singh, M.; Rizvi, M.M.A. Phytochemical Composition of Cassia fistula Fruit Extracts and its Anticancer Activity Against Human Cancer Cell Lines. J. Boil. Act. Prod. Nat. 2014, 4, 158–170. [Google Scholar] [CrossRef]
- Agarwal, H.; Kumar, S.V.; Rajeshkumar, S. A review on green synthesis of zinc oxide nanoparticles—An eco-friendly approach. Resour. Effic. Technol. 2017, 3, 406–413. [Google Scholar] [CrossRef]
- Anand, G.T.; Renuka, D.; Ramesh, R.; Anandaraj, L.; Sundaram, S.J.; Ramalingam, G.; Magdalane, C.M.; Bashir, A.K.H.; Maaza, M.; Kaviyarasu, K. Green synthesis of ZnO nanoparticle using Prunus dulcis (Almond Gum) for antimicrobial and supercapacitor applications. Surf. Interfaces 2019, 17, 100376. [Google Scholar] [CrossRef]
- Sani, I.K.; Pirsa, S.; Tağı, Şeref. Preparation of chitosan/zinc oxide/Melissa officinalis essential oil nano-composite film and evaluation of physical, mechanical and antimicrobial properties by response surface method. Polym. Test. 2019, 79, 106004. [Google Scholar] [CrossRef]
- Noshirvani, N.; Ghanbarzadeh, B.; Mokarram, R.R.; Hashemi, M.; Coma, V. Preparation and characterization of active emulsified films based on chitosan-carboxymethyl cellulose containing zinc oxide nano particles. Int. J. Boil. Macromol. 2017, 99, 530–538. [Google Scholar] [CrossRef]
- Jayakumar, A.; Heera, K.V.; Sumi, T.S.; Joseph, M.; Mathew, S.; Praveen, G.; Nair, I.C.; Radhakrishnan, E.K. Starch-PVA composite films with zinc-oxide nanoparticles and phytochemicals as intelligent pH sensing wraps for food packaging application. Int. J. Boil. Macromol. 2019, 136, 395–403. [Google Scholar] [CrossRef]
- Shankar, S.; Teng, X.; Li, G.; Rhim, J.-W. Preparation, characterization, and antimicrobial activity of gelatin/ZnO nanocomposite films. Food Hydrocoll. 2015, 45, 264–271. [Google Scholar] [CrossRef]
- Mohd Ishak, Z.A.; Mat Taib, R. Chapter 3—Multifunctional polymer composites using natural fiber reinforcements. In Multifunctionality of Polymer Composites; Friedrich, K., Breuer, U., Eds.; William Andrew Publishing: Oxford, UK, 2015; pp. 71–101. [Google Scholar] [CrossRef]
- Rahman, P.M.; Mujeeb, V.A.; Muraleedharan, K.; Thomas, S.K. Chitosan/nano ZnO composite films: Enhanced mechanical, antimicrobial and dielectric properties. Arab. J. Chem. 2018, 11, 120–127. [Google Scholar] [CrossRef]
- Kanmani, P.; Rhim, J.-W. Properties and characterization of bionanocomposite films prepared with various biopolymers and ZnO nanoparticles. Carbohydr. Polym. 2014, 106, 190–199. [Google Scholar] [CrossRef] [PubMed]
- Carneiro, J.; Tedim, J.; Ferreiraa, M. Chitosan as a smart coating for corrosion protection of aluminum alloy 2024: A review. Prog. Org. Coatings 2015, 89, 348–356. [Google Scholar] [CrossRef]
- Liu, F.; Avena-Bustillos, R.J.; Zhong, F.; Chiou, B.-S.; Zhang, Y.; Li, Y.; McHugh, T. Study of combined effects of glycerol and transglutaminase on properties of gelatin films. Food Hydrocoll. 2017, 65, 1–9. [Google Scholar] [CrossRef]
- Sofla, M.S.K.; Mortazavi, S.; Seyfi, J. Preparation and characterization of polyvinyl alcohol/chitosan blends plasticized and compatibilized by glycerol/polyethylene glycol. Carbohydr. Polym. 2020, 232, 115784. [Google Scholar] [CrossRef]
- Nasreen, Z.; Khan, M.A.; Mustafa, A.I. Improved Biodegradable Radiation Cured Polymeric Film Prepared from Chitosan-Gelatin Blend. J. Appl. Chem. 2016, 2016, 1–11. [Google Scholar] [CrossRef]
- Rodrigues, C.; De Mello, J.M.M.; Dalcanton, F.; Macuvele, D.L.P.; Padoin, N.; Fiori, M.A.; Soares, C.; Riella, H.G. Mechanical, Thermal and Antimicrobial Properties of Chitosan-Based-Nanocomposite with Potential Applications for Food Packaging. J. Polym. Environ. 2020, 28, 1216–1236. [Google Scholar] [CrossRef]
- Murali, S.; Kumar, S.; Koh, J.; Seena, S.; Singh, P.; Ramalho, A.; Sobral, A.J.F.N. Bio-based chitosan/gelatin/Ag@ZnO bionanocomposites: Synthesis and mechanical and antibacterial properties. Cellulose 2019, 26, 5347–5361. [Google Scholar] [CrossRef]
- Kraśniewska, K.; Galus, S.; Gniewosz, M. Biopolymers-Based Materials Containing Silver Nanoparticles as Active Packaging for Food Applications–A Review. Int. J. Mol. Sci. 2020, 21, 698. [Google Scholar] [CrossRef]
- Amjadi, S.; Emaminia, S.; Davudian, S.H.; Pourmohammad, S.; Hamishehkar, H.; Roufegarinejad, L. Preparation and characterization of gelatin-based nanocomposite containing chitosan nanofiber and ZnO nanoparticles. Carbohydr. Polym. 2019, 216, 376–384. [Google Scholar] [CrossRef]
- Al-Naamani, L.; Dutta, J.; Dobretsov, S. Nanocomposite Zinc Oxide-Chitosan Coatings on Polyethylene Films for Extending Storage Life of Okra (Abelmoschus esculentus). Nanomaterials 2018, 8, 479. [Google Scholar] [CrossRef] [PubMed]
- Munnawar, I.; Iqbal, S.S.; Anwar, M.N.; Batool, M.; Tariq, S.; Faitma, N.; Khan, A.L.; Khan, A.U.; Nazar, U.; Jamil, T.; et al. Synergistic effect of Chitosan-Zinc Oxide Hybrid Nanoparticles on antibiofouling and water disinfection of mixed matrix polyethersulfone nanocomposite membranes. Carbohydr. Polym. 2017, 175, 661–670. [Google Scholar] [CrossRef] [PubMed]
- Haldorai, Y.; Shim, J.-J. Chitosan-Zinc Oxide hybrid composite for enhanced dye degradation and antibacterial activity. Compos. Interfaces 2013, 20, 365–377. [Google Scholar] [CrossRef]
- Qi, K.; Cheng, B.; Yu, J.; Ho, W. Review on the improvement of the photocatalytic and antibacterial activities of ZnO. J. Alloy. Compd. 2017, 727, 792–820. [Google Scholar] [CrossRef]
- Kumar, S.; Singh, M.; Halder, D.; Mitra, A. Mechanistic study of antibacterial activity of biologically synthesized silver nanocolloids. Colloids Surfaces A Physicochem. Eng. Asp. 2014, 449, 82–86. [Google Scholar] [CrossRef]
- Naskar, A.; Khan, H.; Sarkar, R.; Kumar, S.; Halder, D.; Jana, S. Anti-biofilm activity and food packaging application of room temperature solution process based polyethylene glycol capped Ag-ZnO-graphene nanocomposite. Mater. Sci. Eng. C 2018, 91, 743–753. [Google Scholar] [CrossRef]

| Hybrid Films | Thickness (µm) | TS (MPa) | EAB (%) |
|---|---|---|---|
| CH/GL (control) | 84.53 a ± 1.83 | 32.02 c ± 0.78 | 20.24 a ± 0.08 |
| CH/GL/ZnO (1%) | 86.35 a,b ± 2.97 | 29.45 b ± 0.59 | 24.03 b ± 0.29 |
| CH/GL/ZnO (2%) | 92.32 c ± 1.02 | 30.87 b ± 0.09 | 27.53 c ± 0.96 |
| CH/GL/ZnO (4%) | 88.61 b ± 0.98 | 26.39 a ± 0.72 | 35.65 d ± 0.71 |
© 2020 by the authors. Licensee MDPI, Basel, Switzerland. This article is an open access article distributed under the terms and conditions of the Creative Commons Attribution (CC BY) license (http://creativecommons.org/licenses/by/4.0/).
Share and Cite
Kumar, S.; Mudai, A.; Roy, B.; Basumatary, I.B.; Mukherjee, A.; Dutta, J. Biodegradable Hybrid Nanocomposite of Chitosan/Gelatin and Green Synthesized Zinc Oxide Nanoparticles for Food Packaging. Foods 2020, 9, 1143. https://doi.org/10.3390/foods9091143
Kumar S, Mudai A, Roy B, Basumatary IB, Mukherjee A, Dutta J. Biodegradable Hybrid Nanocomposite of Chitosan/Gelatin and Green Synthesized Zinc Oxide Nanoparticles for Food Packaging. Foods. 2020; 9(9):1143. https://doi.org/10.3390/foods9091143
Chicago/Turabian StyleKumar, Santosh, Abhinab Mudai, Barnali Roy, Indra Bhusan Basumatary, Avik Mukherjee, and Joydeep Dutta. 2020. "Biodegradable Hybrid Nanocomposite of Chitosan/Gelatin and Green Synthesized Zinc Oxide Nanoparticles for Food Packaging" Foods 9, no. 9: 1143. https://doi.org/10.3390/foods9091143
APA StyleKumar, S., Mudai, A., Roy, B., Basumatary, I. B., Mukherjee, A., & Dutta, J. (2020). Biodegradable Hybrid Nanocomposite of Chitosan/Gelatin and Green Synthesized Zinc Oxide Nanoparticles for Food Packaging. Foods, 9(9), 1143. https://doi.org/10.3390/foods9091143








